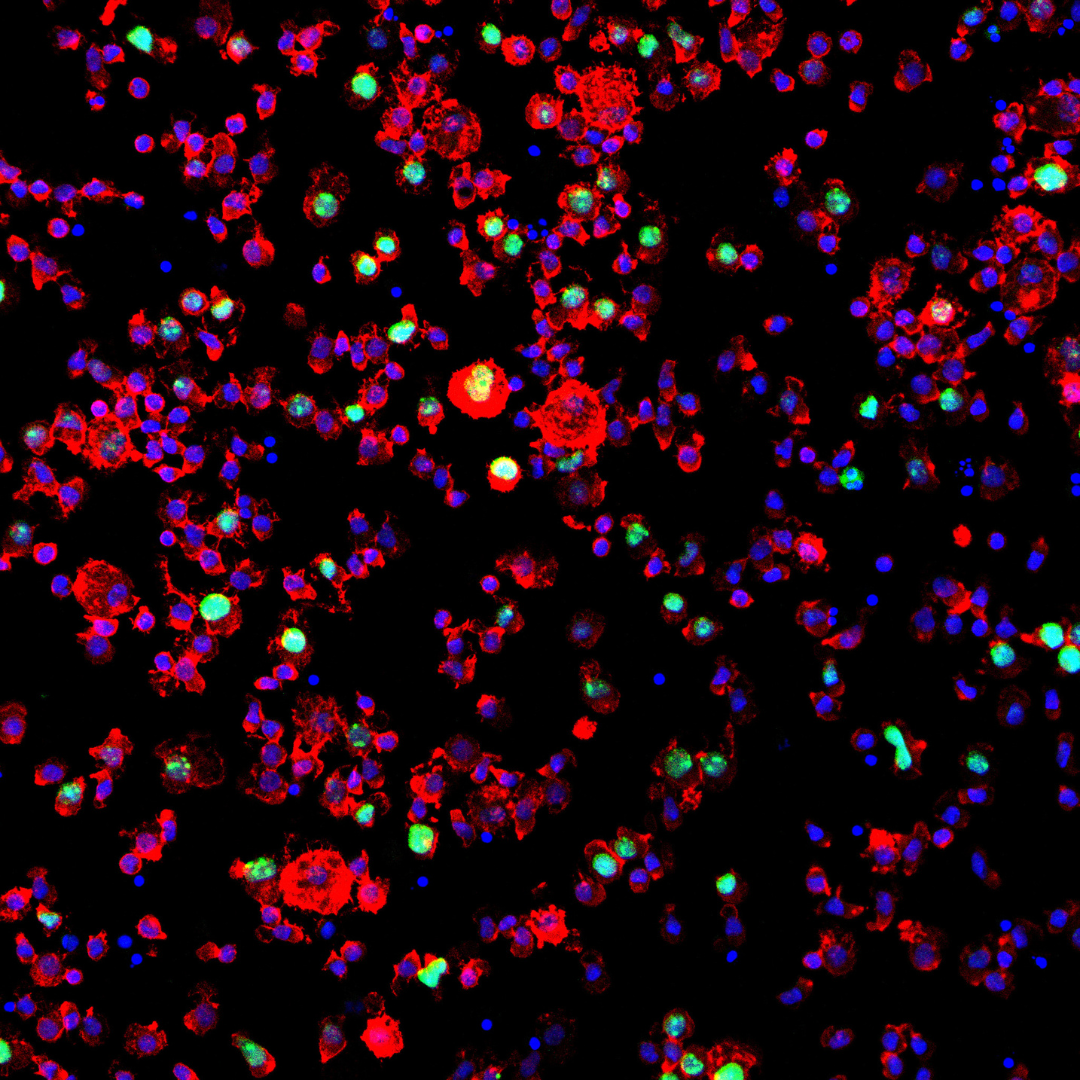

Selected by: Aliaksandr "Sasha" Kanavalau
KTR to nie tylko złoto i best of. Mnóstwo wybitnych prac otrzymuje srebro, brąz czy nominacje. Na które warto zwrócić uwagę? O to zapytaliśmy naszych jurorów, którzy poświęcili mnóstwo godzin na przegląd i dyskusję o zgłoszeniach. Waszym przewodnikiem po nagrodach z kategorii Ilustracja będzie juror Aliaksandr Sasha Kanavalau Creative Art Director ColorOffOn / ArtSaszka.

SunRoof
Za dbałość o detal, świetny design, dobre oko i styl jakiego nie powstydziłby się światowy rynek. Cieszę się że z taką pieczołowitością i z designerskim podejściem powstają filmy dla prawdziwych klientów. Chciałbym oglądać więcej tak dobrze wykonanych i zanimowanych ilustracji.
Seria opakowań na zapałki i kadzidła
Za lekkość, prostotę i humor. Ta praca pokazuje ile tak naprawdę waży w reklamie pomysł. Nie wszystko musi być skomplikowane, wielkie, mosiężne w formie. Lekka grafika, prosta kreska, szczypta humoru i mamy zapamiętywalne, unikatowe ilustracje. Czego chcieć więcej? Seria opakowań na zapałki i kadzidła zasługuje na wyróżnienie właśnie za doskonałą prostotę, która nie zmieniła się w prostactwo.
Buy My Cancer
Za nietypowe myślenie i nieszablonowe podejście wykorzystujące sztukę i ilustrację w nowoczesnym świecie technologii. Szczególnie warto to docenić, bo dla obu bardzo ważne są nowe drogi dotarcia do odbiorcy i fajnie, że twórcy kampanii o tym myślą. Wyróżnienie należy się za nowoczesne podejście, za “spojrzenie inaczej”, za przecieranie nowych dróg wykorzystania ilustracji i znalezienie nowego miejsca we współczesnym, zdigitalizowanym świecie. I na koniec, oczywiście, za szczytny cel, bo jeśli ilustracja może pomóc, to cieszy mnie to jeszcze bardziej.